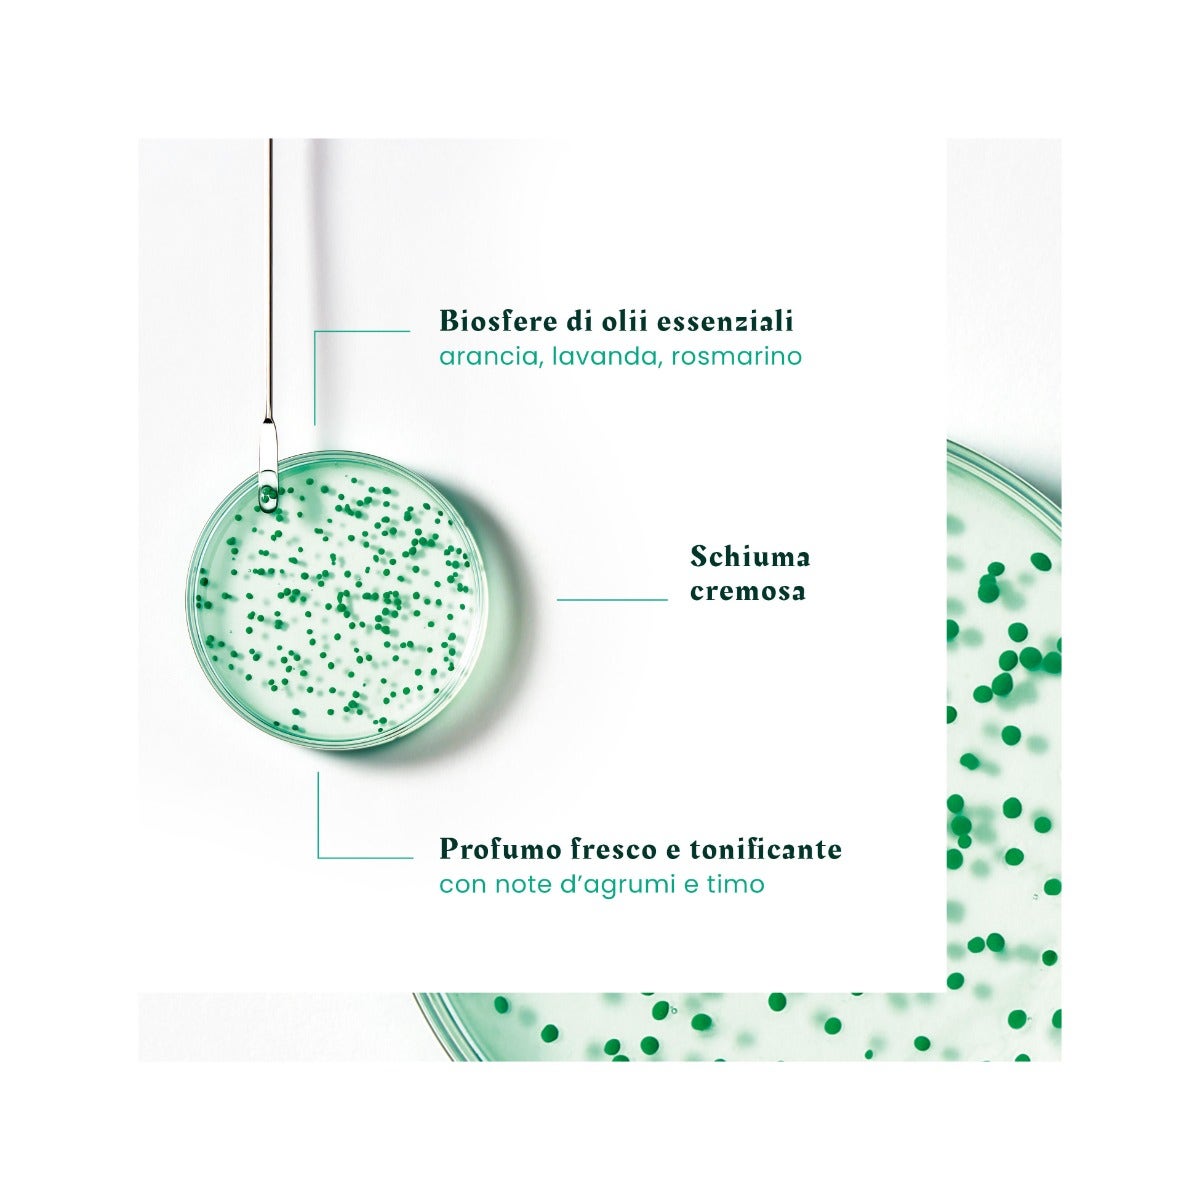
René Furterer Forticea Shampoo Fortificante Rivitalizzante 200ml-4

René Furterer Forticea Shampoo Fortificante Rivitalizzante 200ml
René Furterer Forticea Shampoo Fortificante Rivitalizzante 200ml
Esaurito
Impossibile caricare la disponibilità del ritiro
Descrizione
Descrizione
Shampoo Fortificante Rivitalizzante
Lo Shampoo fortificante rivitalizzante è formulato per tutti i tipi di capelli. Associa il Guaranà, potente energizzante naturale, con Vitamine B5 e B3, chiamata anche Niacinamide, e con i preziosi poteri delle Biosfere che racchiudono un cocktail di Oli essenziali stimolanti, per risvegliare la forza dei capelli.
Fin dalla radice, l'apporto di vitamine ed elementi energetici è intensificato per una fibra del capello più forte, più resistente, più bella.
I capelli sono rinforzati e pieni di energia. Leggeri e facili da acconciare, i capelli hanno una buona tenuta. 97% di ingredienti di origine naturale.
Senza silicone, senza tensioattivi solfatati. Formula biodegradabile*.
*Secondo il test OECD 301B.
Per la raccolta differenziata degli imballaggi dopo l'utilizzo, consultare la pagina del prodotto sul sito di marca.
Benefici
• LAVA DELICATAMENTE: formula ricca in olii essenziali stimolanti e purificanti.
• FONTE DI FORZA E VIGORE: rafforzati quotidianamente, i capelli sono più vigorosi e facili da mettere in piega.
• UNA SENSORIALITÀ TONIFICANTE: la capigliatura è avvolta da un profumo dalle note vibranti di energia.
Modalità d'uso
Emulsionare sul cuoio capelluto bagnato e massaggiare delicatamente con movimenti circolari.
Lasciare in posa da 1 a 3 minuti. Risciacquare.
Ingredienti
WATER (AQUA)*. LAURYL GLUCOSIDE*. SODIUM COCOYL ALANINATE*. COCO-BETAINE. AGAR*. ALGIN*. BENZOIC ACID. CAFFEINE. CALCIUM GLUCONATE. CELLULOSE*. CELLULOSE GUM*. CHROMIUM HYDROXIDE GREEN (CI 77289). CHROMIUM OXIDE GREENS (CI 77288). CITRIC ACID*. CITRUS AURANTIUM DULCIS (ORANGE) OIL (CITRUS AURANTIUM DULCIS OIL)*. FRAGRANCE (PARFUM). GLUCONOLACTONE*. GLYCERIN*. GREEN 3 (CI 42053). HYDROXYPROPYL GUAR HYDROXYPROPYLTRIMONIUM CHLORIDE. LAVANDULA ANGUSTIFOLIA (LAVENDER) OIL (LAVANDULA ANGUSTIFOLIA OIL)*. LAVANDULA HYBRIDA OIL*. LIMONENE*. LINALOOL*. MALTODEXTRIN*. METHYL GLUCOSE DIOLEATE. NIACINAMIDE. PANTHENOL. PANTOLACTONE. PAULLINIA CUPANA SEED EXTRACT*. PROPANEDIOL. ROSMARINUS OFFICINALIS (ROSEMARY) LEAF OIL (ROSMARINUS OFFICINALIS LEAF OIL)*. SODIUM BENZOATE. TALC. TOCOPHEROL. TOCOPHERYL ACETATE. YELLOW 5 (CI 19140)
Formato
200ml
Spedizione
Spedizione
TABELLA SPEDIZIONE
Spedizioni veloci tramite corriere espresso GLS o BARTOLINI o SDA.
| PAESE | DETTAGLI | COSTI |
| Italia | Spedizioni entro 1-2 giorni lavorativi. | € 4,99 Gratuite per ordini > di € 59,99 |
| Estero | Germania | € 13,00 |
| Estero | Austria, Belgio, Liechtenstein, Lussemburgo, Olanda, Slovenia | € 15,00 |
| Estero | Svizzera | € 15,00 + € 40,00 DAZI DOGANALI |
| Estero | Danimarca, Francia, Grecia, Serbia, Spagna, Ungheria, Regno Unito | € 18,00 |
| Estero | Bulgaria, Croazia, Estonia, Lettonia, Lituania, Norvegia, Polonia, Portogallo, Repubblica Ceca, Romania, Svezia | € 25,00 |
Contrassegno: costo aggiuntivo € 6, disponibile solo per l'Italia.